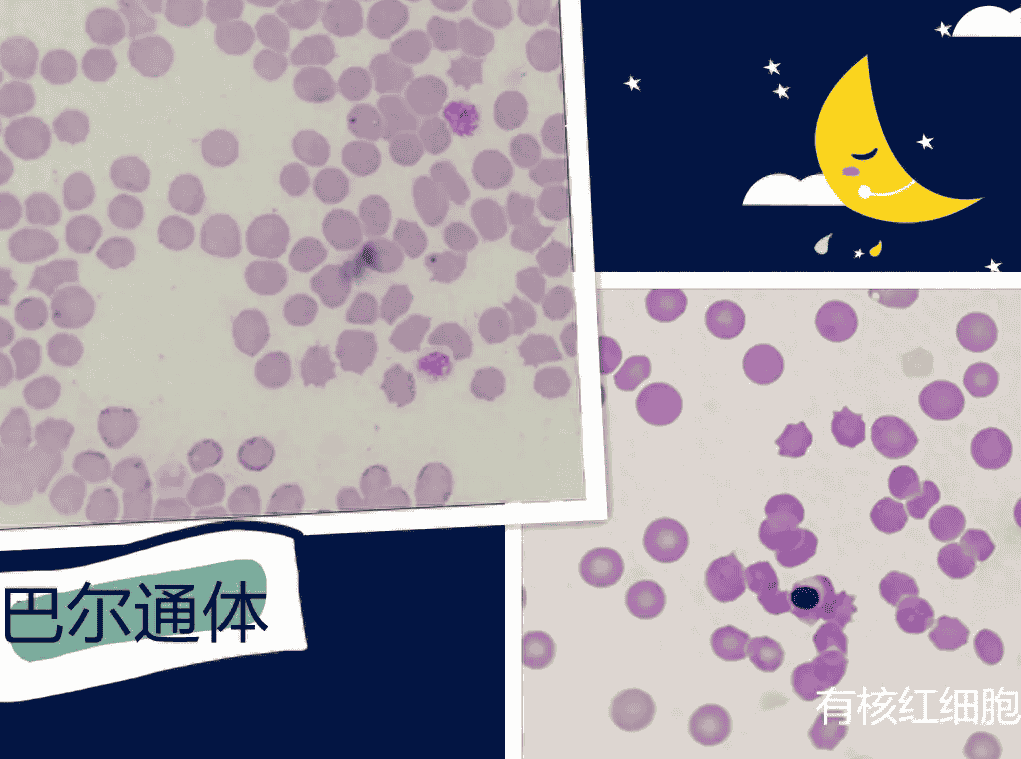

铲屎官注意了!会被猫咪传染的六种疾病,你都了解吗?

关于猫会不会传染给人疾病的问题我相信这些肯定是铲屎官最关心的问题,铲屎官们做好笔记啦;小编结合网上查询和咨询宠物医生所得到的资料一一分享给大家哈,其实咱们家庭饲养的大多数猫咪得的疾病是不会传染给人的,只有极少数会传染给人,下面我就给大家分享六种人猫都会共患病的情况,铲屎官们看完一定要及时注意提前预防哦!
一、弓形虫传染
这个相信就算不养猫的人都听过弓形虫传染,特别家里有老人的情况下,只要铲屎官怀孕了或者家里人有人怀孕的话,大部分父母长辈啥的直接下达禁猫令,上演了一幕幕人猫分离的惨剧。

所以说弓形虫可以说是养猫家庭最害怕的一种病了,尤其是家里有孕妇之后,很多养的好好的猫咪就会被遗弃(大部分迫于长辈的压力),因为在怀孕期间如果感染弓形虫病的话,是会导致腹中胎儿一个严重的先天缺陷的进而导致胎儿流产。

不可否认弓形虫它是一种寄生在猫咪身上的“虫子”,而且也的确会传染弓形虫给人类,不过各位铲屎官注意啦,笔记本准备好了,它的传播途径主要是通过猫咪的粪便传染的,而且如果我们人类想要感染上猫咪身上的弓形虫病,小编可以很负责任的说,那难度是相当大的;起码你要做到以下四点:
1,必须是猫咪先感染了弓形虫;
2,我们人必须吃猫咪的大便(对,你没看错,是吃大便),喝猫尿都没有用,必须是猫咪的大便;
3,还不能吃刚拉出来的新鲜热气腾腾的猫大便,而必须吃那种超过24小时以上的隔夜还没发酵的猫大便才行;
4,猫咪其实一辈子也就只会排一次弓形虫卵,所以,如果人想传染上弓形虫卵的话,必须顿顿都吃猫大便,才有可能感染上弓形虫病(小编yue了~)。

所以怎么说呢,除非你是天生的天煞孤星倒了八辈子血霉的铲屎官,才能第一次吃猫大便,一发入魂就感染了弓形虫,那我也觉的没话讲了,感觉去路边刮刮乐吧,估计中奖率都比这个高!
二、猫癣
猫癣我相信很多铲屎官都不陌生,相信大部分铲屎官家里的猫咪或多或少都得过,因为猫癣是猫咪很常见的皮肤病,它是由真菌引起的,其实和我们人类的脚气是很像的,猫咪得了猫藓一般都是以圆形或者椭圆形来呈现的藓斑,而且皮肤周围还会掉毛很好辨认,铲屎官可以用治疗猫藓的药膏外涂再加上吃一些口服药或者泡药浴基本就可以很容易治疗好的。

为什么说这个会传染人呢?如果铲屎官是免疫力低下和过敏体质的人是十分容易被患了猫藓的猫咪传染的,轻则会出现皮肤瘙痒出现红疹子,如果严重的话就会脱发、皮肤病变等等,所以说铲屎官们平时一定要多锻炼身体不要宅在家里,提高自身免疫力和保持家里环境干燥,注重猫咪喝自己居住环境的卫生清洁是非常重要的,相信只要做到这些,一般人会很快就会好转的!

三、狂犬病
狂犬病这个基本都是养宠人谈之色变的一种病,因为这个传染病是以只要人类感染上就百分比死亡率而闻名,狂犬病是由狂犬病毒感染的急性传染病,这些病毒主要存在于神经系统。

如果感染上这种病的人狗猫,潜伏期一般都是二十天到九十天不等,期间患病的人猫狗会出现恐水、恐风、恐声、呼吸困难或者全身抽搐这样的症状,致死率是百分之百的,主要传播途径是通过体液,比如被发病的猫狗咬伤抓伤,所以如果出现被猫狗抓伤咬伤的情况,养宠人不要觉得没啥事,需要立刻及时的去医院接种狂犬疫苗!

不过猫咪如果是在健康的状态下并不会传染狂犬病的,所以说如果你是被家里健健康康的猫咪抓伤的话,铲屎官不用紧张,况且我相信铲屎官每年也会给自家猫咪打狂犬疫苗对吧,所以更加可以放一百个心啦!
四、沙门氏菌感染
沙门氏菌是一种可能导致猫咪肠道感染的细菌,一般感染这种细菌是由于喂食猫咪吃生肉或者猫咪出去吃了携带这种细菌的野生小动物感染的,这个也是会传染给人的,至于传播途径就是猫咪的粪便了,所以铲屎官铲屎的时候注意啦,我们人类如果感染了沙门氏菌会引起我们的腹泻、腹痛、发烧、呕吐、腹胀的症状,特别是家里有老人和小孩的家庭要注意了,因为这类人群抵抗力普遍低下,所以他们很有可能更容易感染到猫咪身上的沙门氏菌的传染,不过看到这里铲屎官们也不用太紧张,一般只要你做好了家庭卫生一般是都不会有问题的哦!

五、寄生虫感染
这里说的寄生虫感染其实是指很多种的,比如说猫咪体外的感染寄生虫就有跳蚤、蜱虫这一类,而体内的就是大家都熟知的绦虫;跳蚤蜱虫这一类相信家养的猫咪一般都不会带出户外玩耍和定期做好驱虫的话,猫咪是很难感染到跳蚤和蜱虫传染给人类的,而绦虫是通过粪便传染给人的,所以铲屎官只要给猫咪铲完屎后立刻去洗手是可以很好的预防的,还有就是定期给猫咪打好预防针做好体内外驱虫,做好自己个人和周围环境的卫生,我前面说的这些都不是事,基本都不会发生传染到人的情况。

六、猫抓病
这个猫爪病其实是一种比较罕见的病,猫爪病其实还有一种叫法就是猫抓热,主要引起猫爪病的病原体是一个叫做巴尔通体的物质引起的,有科学研究表明,有10%的家养宠物猫和33%的户外流浪猫的血液中会携带这种巴尔通体。
传播途径一般都是人被猫咪抓咬或者与猫咪有密切接触之后会感染这种猫爪病,我们人类如果感染了这个猫爪病的话,会在三天到七天之后,之前被猫咪抓伤的地方会出现局部的化脓性炎症,比如说红斑或者丘疹,有时候甚至会出现面头部肉芽肿性或者是化脓性的淋巴结病变,这一套专业术语小编听着就觉得很可怕,被传染的人主要症状会表现出低热、头痛、打寒颤、全身乏力、厌食和呕吐。

如果得了猫爪病及时地去治疗的话,一般都是没有什么太大的问题,不过如果是自身免疫力比较差的人才会出现严重的全身并发症,所以这里小编再插一句,平时不要宅家里,要出去锻炼身体跑跑步,提高自身免疫力哦。

所以如果刚刚饲养猫咪的话,一定要提前带猫咪去宠物医院那边做一个详细的全身检查,在确定健康的情况下,再把猫咪带回家,还有就是饲养猫咪,一定需要及时定期的给猫咪打疫苗,做好体内外的驱虫,这样不止对猫咪负责,也对家人负责哦!
相关阅读
-
家里泰迪若有这4种行为,证明你得罪它了,看看你中招没有
第一种:不喜欢你的靠近,都是喜欢与自己的主人亲近的,一旦它出现了这种不喜欢你靠近的行为,你得罪过它,它已经记到了心里,看看你中招没有?第二种:报复你,这小家伙的心眼是很小的,如果你被它记恨了,那么它很可能就会伺机找你报复,就比如说随地大小便
-
狗狗绝育真的这么可怕?违反自然规律,还不人道?|健康
母犬需要绝育吗?答案众说纷纭。所有的手术,即使是对于像绝育这样的小手术来说,也会存在一定的风险。但是,调查的数据显示,未做绝育手术的母犬,健康更易受到疾病的危害。图自:ins@allaboutthebas01.绝育前后母犬患病几率比较其实大
-
狗狗过了几岁不能绝育?3分钟告诉你
有些宠主想让自家狗生几胎小狗,再带它绝育,但生着生着,很多宠主都不知道,狗狗目前的年纪能不能绝育了!所以今天就花3分钟告诉你,狗狗多了几岁不能绝育!首先要知道,绝育是什么意思。所谓绝育,就是摘除狗狗体内与生殖相关的器官,公狗是进行体外切除,
-
家里养泰迪,如果有四个习惯要及时制止,不然会变得无法无天
都说狗是人类非常忠诚的朋友,很多人都喜欢养狗,现在几乎每个人家里都有一条狗。对于很多人来说,大型犬是非常不方便的,不仅遛狗的时候容易被狗溜,在家里给狗洗澡也不方便,所以很多人都会选择小型犬,这时候可爱的泰迪就成了人们的首选。泰迪是非常可爱的
-
泰迪犬真的好养吗?不要被那些“谎言”骗了,盘点它的六大缺点
人人都说泰迪犬体型小,吃的少,而且不掉毛,所以很容易饲养,但是千万不要被谎言骗了,今天就来说说泰迪犬的缺点。缺点一:体型小,但是精力过于旺盛泰迪犬的性格实在是太活泼了,和其他小型犬比起来,泰迪犬的精力要更加旺盛,经常会吵到主人和邻居。如果没
-
在狗市场,800元买下这只泰迪,喂养不久后,我的噩梦就开始了
稿文如下:不久前,我在外面逛街,刚好走到狗狗交易市场,因为我一直想养一只狗狗,所以心痒痒的,就进去了。缘分是真的奇妙,我一眼就挑中了了泰迪,它的价格起初还是有点高的,我和老板嘴皮子都讲破了,最终以800元买下这只泰迪,我是非常开心的。我把泰

